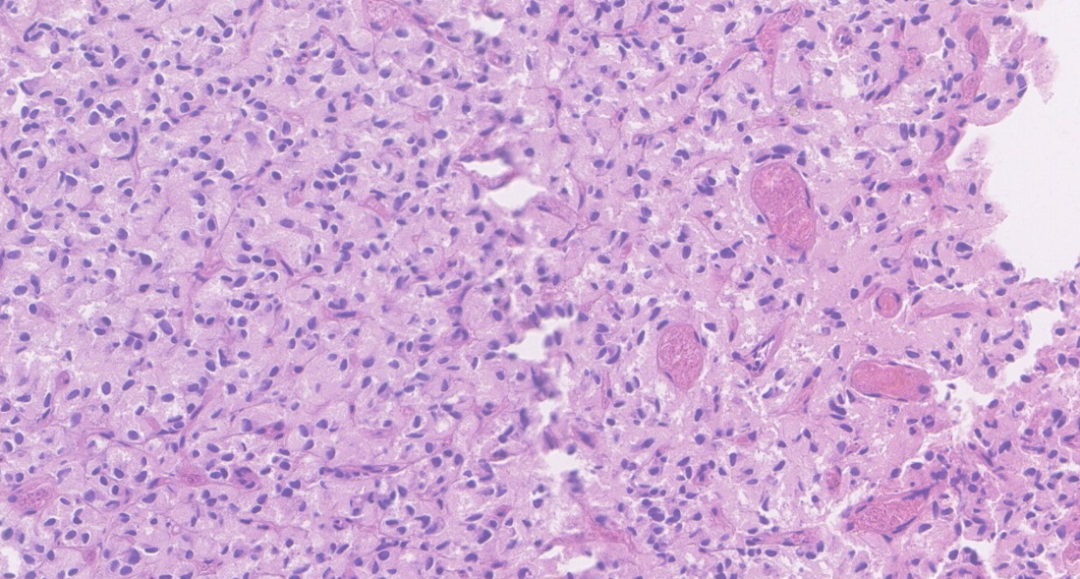
20250417_w6v0t
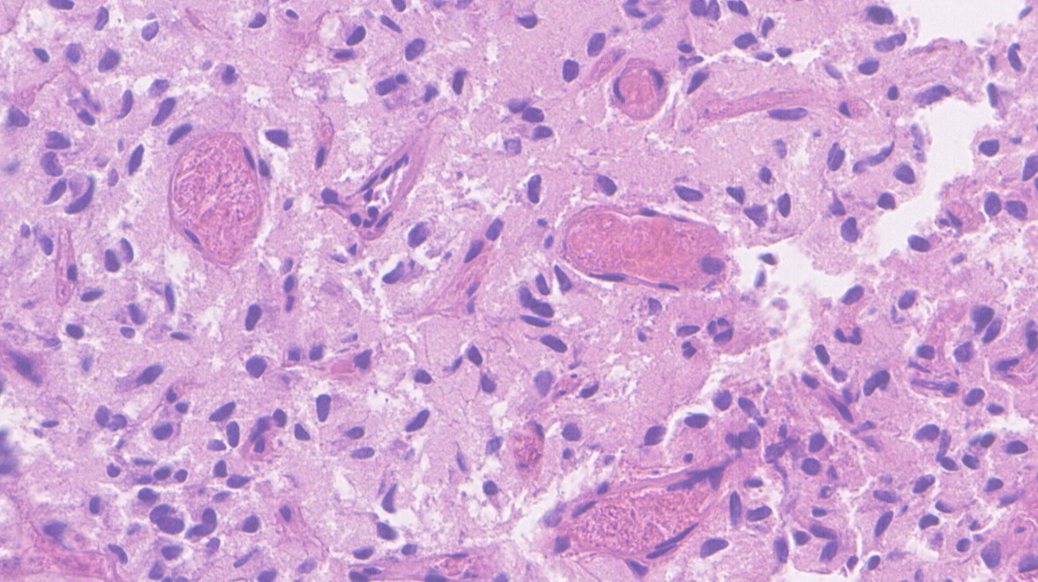
20250417_xowjg

引言
副神经节瘤(Paraganglioma, PGL)是一种相对少见的神经内分泌肿瘤,可能发生在身体的多个部位。当它发生在膀胱时,其诊断可能面临挑战。准确的诊断是制定有效治疗方案的第一步。本文将结合一例具体病例,深入探讨膀胱副神经节瘤的诊断流程和关键要点。
病例介绍
基本情况:
患者为一位68岁女性,因突发性右侧腰背部剧痛就诊。初步腹部CT平扫显示右侧输尿管结石伴随上段扩张及右肾积水。在症状缓解后进行的CTU检查中,意外发现膀胱前壁存在一处结节。
既往病史: 患者十余年前曾接受子宫肌瘤切除手术。


影像学检查提示:膀胱右前壁占位性病变
手术探查:
手术过程中,在膀胱右前壁观察到一个位于黏膜下的椭圆形肿物,基底较宽,尺寸约为1.5cm。
大体检查:
送检的“膀胱新生物”标本为灰白、灰褐色碎组织,合计大小约1.5×1.0×0.2cm。
病理学检查
镜下观察:

图中红箭头指示区域为带有烧灼痕迹的正常黏膜固有层,其余大部分为形态较一致的肿瘤组织。

低倍镜下显示肿瘤富含血窦结构。
肿瘤细胞胞浆呈淡粉色,间质中可见丰富的纤细纤维血管束。
肿瘤细胞核形态为圆形或卵圆形,异型性不明显,核染色深,未观察到明显核仁。
诊断思路分析:
面对富含血管的病变,病理诊断需考虑多种可能性:
- 血管源性肿瘤:如血管瘤等。
- 间质富于血管的非血管源性肿瘤:如肝细胞癌、肾细胞癌、神经内分泌肿瘤、腺泡状软组织肉瘤等。
- 血管作为肿瘤成分之一的非血管源性肿瘤:如鼻咽血管纤维瘤等。
在膀胱部位,最常见的肿瘤是尿路上皮来源的病变。然而,本病例的形态学特征并不典型支持尿路上皮癌,因此需要借助免疫组化进行进一步鉴别。
免疫组化结果:








免疫组化染色显示肿瘤细胞表达情况如下:
- 神经内分泌标记物:CgA (+), SYN (+), CD56 (+)
- 上皮标记物:AE1/AE3 (-)
- 尿路上皮标记物:GATA3 (-), P63 (-)
- 其他标记物:CD68 (-), SDHB (蛋白表达正常), S-100 (-), CD34 (-, 间质血管内皮+), SSTR2A (-), TTF-1 (-)
- 增殖指数:Ki-67 (1%)
最终病理诊断:
综合肿瘤位于膀胱黏膜下、富含血窦的形态学特征以及免疫组化结果(神经内分泌标记物阳性,上皮标记物阴性),最终诊断为:副神经节瘤(Paraganglioma, PGL)。
副神经节瘤(PGL)概述
定义:
副神经节瘤是一种起源于神经嵴祖细胞的神经内分泌肿瘤,这些细胞与交感神经系统相关联。
恶性潜能:
根据第五版WHO泌尿系统肿瘤分类和神经内分泌肿瘤分类,PGL的ICD-O编码为3,意味着其具有恶性潜能,可能发生转移或复发,需要长期密切随访。
临床特征:
- 多数PGL为功能性肿瘤,可分泌过量儿茶酚胺,导致高血压、心悸、出汗、焦虑等症状。
- 肿瘤本身也可引起局部压迫症状,如发生在膀胱可能导致尿频、尿急等泌尿系统症状。
- 发病年龄广泛,常见于50-70岁。若在年轻患者中发现,需警惕遗传性综合征的可能性。
大体病理特点:
PGL无特异性大体外观。膀胱PGL可发生于膀胱任何部位,通常位于黏膜下,少数可向腔内呈外生性生长。
组织形态学特点:
- 部位: 膀胱PGL常位于黏膜下,有助于与起源于黏膜表面的尿路上皮病变鉴别。
- 生长模式: 典型的PGL呈现“Zellballen”(细胞球)样巢状结构,肿瘤细胞巢被纤细的毛细血管网分隔,巢周可见支持细胞。

典型的Zellballen样巢状生长模式 [引自第五版泌尿WHO]
- 细胞特点: 肿瘤细胞通常胞浆嗜酸性,核呈圆形或卵圆形。少数情况下可见核多形性或深染,需与尿路上皮癌、前列腺癌或肾细胞癌鉴别。
- 间质特点: 间质富含纤细的毛细血管网,支持细胞围绕在肿瘤细胞巢周围。
免疫组化特征:
- 神经内分泌标记: 肿瘤细胞通常强阳性表达 Syn、CgA、CD56 等。
- 支持细胞标记: 巢周的支持细胞通常表达S100、SOX10。
- 上皮标记: PGL 通常不表达 角蛋白(如AE1/AE3)等上皮标记物。
- SDHB标记: SDHA/B/C/D/AF2基因(统称SDHx)的突变或甲基化均可导致SDHB蛋白表达异常(缺失或减弱)。SDHB表达异常提示可能存在SDH缺陷相关的遗传性肿瘤综合征。本例患者SDHB蛋白表达正常。






SDHB免疫组化结果判读示例:A图为正常表达(胞浆颗粒状强阳性),B-F图均为不同模式的表达异常 [引自PMID:35546442]
- GATA3标记: 需要注意,部分PGL可能表达GATA3,因此 不能单独依靠GATA3阴性来排除尿路上皮癌。

部分副神经节瘤可弥漫表达GATA3 [引自第五版泌尿WHO]
诊断标准(WHO):
- 基本标准: 具备典型的副神经节瘤形态学特征。
- 辅助标准: 神经内分泌标记物阳性;检测到肿瘤相关的特异性基因改变;临床或生化检查证实儿茶酚胺分泌增多;影像学检查支持。
相关的遗传综合征:
约30-40%的PGL/嗜铬细胞瘤与遗传易感基因突变相关,常见的综合征包括:
- 多发性内分泌肿瘤综合征1型 (MEN1)
- 多发性内分泌肿瘤综合征2型 (RET)
- 多发性内分泌肿瘤综合征5型 (MAX)
- VHL综合征 (VHL)
- SDH缺陷肿瘤综合征 (SDHx)
- 神经纤维瘤病1型 (NF1)
(本例患者为68岁老年女性,SDHB蛋白表达正常,无其他相关症状或体征,影像学未发现其他部位肿瘤,因此遗传综合征的可能性较低。)
鉴别诊断
膀胱副神经节瘤需要与以下几种膀胱肿瘤进行鉴别:
- 尿路上皮癌:特别是巢状或大巢状亚型,可能形态温和,但预后较差。
- 通常侵犯固有肌层。
- 免疫组化:通常表达上皮标记物(如AE1/AE3)和GATA3,而神经内分泌标记物阴性。

巢状亚型浸润性尿路上皮癌示例 [引自第五版泌尿WHO]
- 分化好的神经内分泌肿瘤(NET):细胞形态一致,圆形,染色质细腻。
- 常有假腺样生长模式。
- 肿瘤周围常伴有尿路上皮改变(如囊性/腺性膀胱炎)。
- 免疫组化:弥漫表达CgA、Syn,Ki-67指数低,但通常表达上皮标记物。

分化好的神经内分泌肿瘤(蓝线下)及其周围的腺性膀胱炎(蓝线上)[引自PMID:33301750]
- 神经内分泌癌(NEC):包括小细胞癌和大细胞癌,细胞异型性大,核分裂像多见,常伴坏死。
- 免疫组化:弥漫表达神经内分泌标记物,Ki-67指数通常很高,且表达上皮标记物。
结语
膀胱副神经节瘤是一种罕见的神经内分泌肿瘤,其诊断依赖于临床、影像、病理形态学和免疫组化的综合判断。准确识别其特征,特别是与尿路上皮癌等常见膀胱肿瘤进行鉴别,对于指导后续治疗和评估预后至关重要。确诊后,患者和家属可能需要进一步了解疾病信息、治疗方案及预后情况,可以通过可靠渠道如MedFind 抗癌资讯 获取相关知识。
参考文献及书籍:
1.WHO Classification of Tumours Editorial Board. Urinary and male genital tumours. Lyon (France): International Agency for Research on Cancer; 2022. (WHO classification of tumours series, 5th ed.; vol.8).
2.Ding CC, Chan S, Mak J, et al. An exploration in pitfalls in interpreting SDHB immunohistochemistry. Histopathology. Aug 2022;81(2):264-269.
3.WHO Classification of Tumours Editorial Board. Endocrine and neuroendocrine tumours. Lyon (France): International Agency for Research on Cancer; 2025. (WHO classification of tumours series, 5th ed.; vol. 10)
4.Rodriguez Pena MDC, Salles DC, Epstein JI, et al. Well-differentiated neuroendocrine tumors of the lower urinary tract: biologic behavior of a rare entity. Hum Pathol. Mar 2021;109:53-58.
